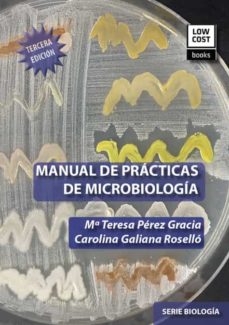
Portada de MANUAL DE PRACTICAS DE MICROBIOLOGIA (3.ª EDICION)

Libros de AUTORES VARIOS, AUTORES VARIOS
Descubre 236 libros de este autor en nuestro catálogo.

MCAS PENSAMIENTO HOMEOTECNICO

SOBRAS ESPECTRALES

REGLAMENTO DEL REGISTRO MERCANTIL ESPAÑOL

POEMAS MITOLOGICOS GUARANIES

ENSAYOS DE ANTROPOLOGIA SOCIAL Y CULTURAL

POST-BECOMING

EL FEUDALISMO

MEMORIA DE LOS APODOS EN MONTEAGUDO

MIGUEL MORAYTA MARTINEZ. DIRECTOR DE CINE

LOS MEJORES 250 VINOS DE ESPAÑA

APRENDEMOS A AMAR ACTIVIDADES ALUMNO 1ºPRIMARIA

PARNASO FILIPINO

DIRECCION FINANCIERA AVANZADA

CONSTITUCION CUBANA DE 1940

UNIDADES DIDACTICAS DE AUDICION Y LENGUAJE

VISAO TERRITORIAL E SUSTENTAVEL DO DESENVOLVIMIENTO.

PATAKINES

HEROTIKOS DE ALAS

NUEVAS APORTACIONES AL ESTUDIO DEL ESCULTOR BARROCO NICOLAS DE BUSSY

BIOETICA, PSIQUIATRIA Y DERECHOS HUMANOS

UTILIZO REGLAS ORTOGRAFICAS 3 MIMO

CODIGO DE COMERCIO DE CUBA

CALABAZAS EN EL TRASTERO

HISTORIA UNIVERSAL SALVAT

NUESTRA COCINA, CATALUÑA

EL RENACIMIENTO

LEO Y COMPRENDO 2 MATERIAL DE APOYO MIMO

RELATOS CON LUPA

PENSAMIENTO POLITICO DE LA EMANCIPACION VENEZOLANA

APRENDEMOS A AMAR ACTIVIDADES ALUMNO 3º PRIMARIA

MUJERES Y SERVICIOS SOCIALES : JORNADAS DEL 8 DE MARZO DEL AYUNTAMIENTO DE MURCIA EN LOS AÑOS 1994 A 1996

TEATRO. PROMOCION 93-97

EXPRESIONISMO ALEMAN : DOCUMENTA DE EXPOSICION

LA LEY ORGANICA DEL ESTADO ESPAÑOL DE 1967

VILLA DE MAZARRON. PREMIOS DEL CONCURSO DE CUENTOS 1982 - 1994

IZQUIERDA DEMOCRATICA

AZORIN Y PETRER

GESTION ECONOMICA DE LAS OBRAS DE EDIFICACION

ARQUITECTURAS DEL LAPSO Y CRONO CARTOGRAFIA DEL REVES

ALMA DE OLIVO OBRAS GANADORAS

LOS MEJORES POETAS FRANCESES

TODAS LAS CONSTITUCIONES CUBANAS DEL SIGLO XIX

VOCES PERDIDAS, VOCES OLVIDADAS

TODAS LAS CONSTITUCIONES CUBANAS

ARQUITECTURA TECNICA Y CALIDAD : LIGEREZA, FUERZA, EQUILIBRIO : JORNADA TECNICA DE ICCE, 1996, GIRONA 19 ABRIL
MANUAL DE PRACTICAS DE MICROBIOLOGIA (3.ª EDICION)

PROYECTO DE CONSTITUCION PROVISORIA PARA EL ESTADO DE CHILE

